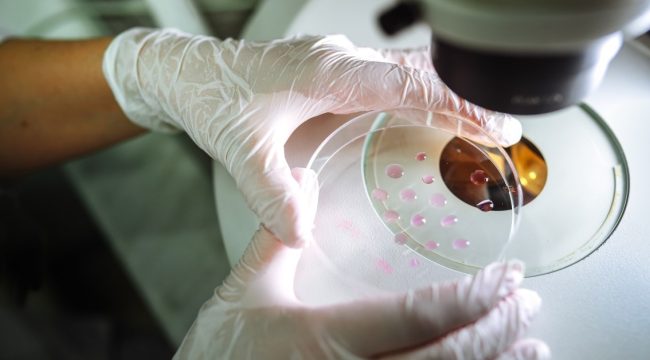
Что делать, если в Библии нет ответов про скрининг эмбрионов? Вызовы новых технологий для церкви

Новости
Глобальный христианский мир на одной странице.

Архиепископ Кентерберийский начнет историческое шестидневное паломничество
Архиепископ Кентерберийский совершит уникальное паломничество по пути из Лондона в Кентербери, готовясь к своей инаугурации.
-
16 мар., 2026
-
08 янв., 2026
- 2
Что делать, если в Библии нет ответов про скрининг эмбрионов? Вызовы новых технологий для церкви
Почему современные церкви молчат о биоэтике, искусственном интеллекте и кризисе семьи, и как отсутствие прямых библейских указаний ведет к моральной растерянности верующих.

-
08 янв., 2026
- 6
Новые сокровища и открытия в Городе Давида: как археология меняет представление о древнем Иерусалиме
Археологические раскопки в самом древнем районе Иерусалима обнаружили гигантский ров, культовый комплекс эпохи Соломона и связали библейские истории с конкретными местами, переписывая историю Святого города.

-
08 янв., 2026
- 8
От современного протестантизма к древним обрядам: почему китайские евангелисты обращаются к православию
Высокообразованные китайские христиане из евангелических общин находят в восточном православии историческую глубину, дисциплину духовной жизни и связь с апостольской традицией, которую они не обнаружили в современном протестантизме.

-
08 янв., 2026
- 5
А если в Библии нет ни слова о скрининге эмбрионов? Церковь перед лицом новых технологий
Почему современные церкви молчат о самых острых биоэтических вызовах — от ЭКО и чат-ботов до суррогатного материнства и редактирования генов.

-
08 янв., 2026
- 3
Папа Лев XIV кардиналам: «Служение начинается с единства и молитвы, а не с частных повесток»
В проповеди на консистории Папа призвал кардиналов к духовному единству и совместному распознаванию воли Божьей, противопоставив это суете современного мира.

-
08 янв., 2026
- 3
Папа Франциск призвал кардиналов к единству и любви как основе миссии Церкви
На открытии чрезвычайной консистории Папа предложил кардиналам отталкиваться от заповеди любви и обсудить приоритеты работы Ватикана на ближайшие два года.

-
08 янв., 2026
- 3
Индия: католическая организация требует от правительства защиты христиан от растущего насилия
Католическая организация Индии бьёт тревогу из-за резкого роста нападений на христиан в период Рождества и требует от властей срочных мер, включая реформу законов.

-
08 янв., 2026
- 2
Индия: католическая организация призывает правительство защитить христиан от растущего насилия
Католическая организация Индии бьет тревогу из-за резкого роста нападений на христиан в период Рождества и требует от властей срочных мер и правовых реформ.

-
08 янв., 2026
- 2
Битва с бездомностью: почему поджог «теплых автобусов» в Берлине — это удар по самым уязвимым
После поджога спасающих от холода автобусов для бездомных и масштабного блэкаута в Берлине обостряется дискуссия о признании борьбы с бездомностью государственной целью и о противоречивой реформе соцвыплат.
-
08 янв., 2026
- 3
Битва с бездомностью: почему поджог «теплых автобусов» в Берлине — лишь верхушка айсберга
Поджог спасающих от холода автобусов для бездомных в Берлине на фоне масштабного отключения электричества обнажает глубину гуманитарного кризиса и спорные методы правительства в борьбе с проблемой.











Рекомендуемые статьи
Бог уже открыл вам Свои планы насчёт вас
12 самых глубоких мыслей Д.Л. Муди о вере
Пять цитат из Библии, которые неправильно поняли
Идеи для вашей следующей христианской татуировки
Десять признаков духовного насилия